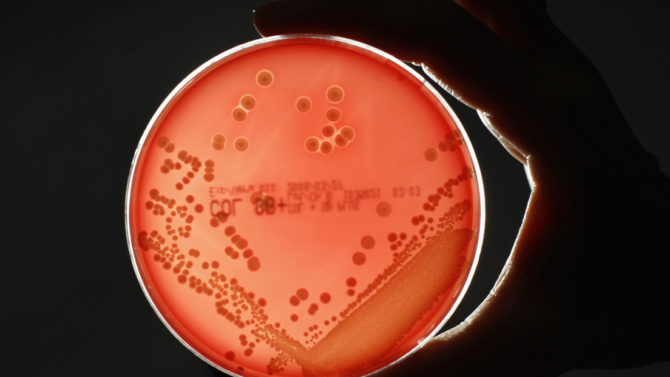

Un hombre se contagia con una bacteria ‘comecarne’ al rasurarse con una afeitadora ajena
Por el simple deseo de corregir unas imperfecciones en su barba, un joven estadounidense de la ciudad de Los Ángeles, en el estado de California, terminó con una infección cutánea potencialmente peligrosa, causada por una bacteria ‘comecarne’, tras confundirse y utilizar la afeitadora de su compañero de piso, informa el New York Post.
Por el simple deseo de corregir unas imperfecciones en su barba, un joven estadounidense de la ciudad de Los Ángeles, en el estado de California, terminó con una infección cutánea potencialmente peligrosa, causada por una bacteria ‘comecarne’, tras confundirse y utilizar la afeitadora de su compañero de piso, informa el New York Post.
Según relató Nick Holterman, de 24 años, días después de la desafortunada confusión comenzó a padecer de una “infección respiratoria superior realmente grave”, y notó una serie de erupciones cutáneas, similares a “picaduras de araña”, en el área de la barbilla, por lo que buscó atención médica.
El galeno que lo atendió le recetó antibióticos para aliviar la infección. Sin embargo, el tratamiento no surtió efecto y la bacteria continúo avanzando sobre su rostro. “Me salieron pústulas y llagas profundas en la barbilla y a lo largo de la línea de la mandíbula”, recordó el paciente.
En vista de que las úlceras aumentaron considerablemente de tamaño, Holterman acudió de nuevo al hospital. En esa segunda visita y tras realizársele una serie de pruebas clínicas, fue diagnosticado y tratado contra impétigo, una enfermedad cutánea altamente contagiosa, causada por estreptococos o estafilococos resistentes a los antibióticos tradicionales, que de no ser tratada adecuadamente puede tener graves consecuencias, incluida la muerte.
“Solo quiero recordarle a todo el mundo que no comparta navajas de afeitar ni utilice las de otras personas. Puedes contraer una bacteria carnívora resistente a los antibióticos, que es extremadamente dolorosa y que supura todo el tiempo”, comentó el joven en respuesta a un video compartido en TikTok y con casi 10 millones de reproducciones, en el que una chica revela haber rasurado el área genital de una amiga, durante una fiesta, utilizando una afeitadora que encontró en el baño.











